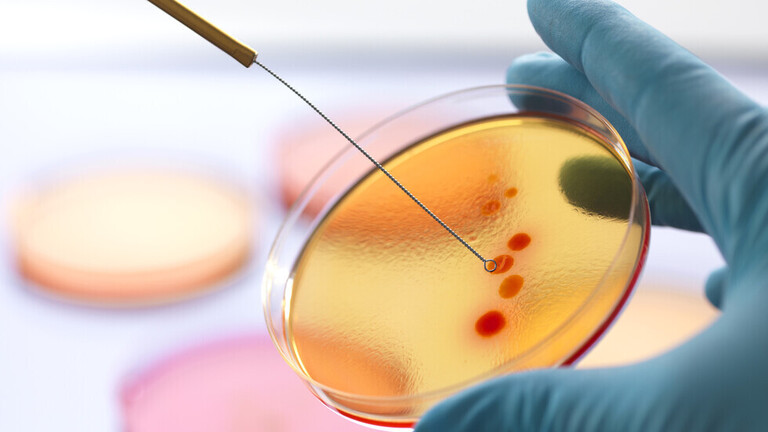
تطوير عقار جديد يقضي على تهديد صحي قد يسبب 10 ملايين وفاة

25
يونيو
1.3 مليار مصاب بالسكري بحلول 2050
529 مليون شخص في العالم مصابون بالسكري، لكن القادم أعظم وأخطر؛ إذ سيلغ العدد 1.3 مليار في سنة 2050 كما أكدت دراسة عالمية جديدة، حذرت من ارتفاع معدلات الإصابة بمرض السكري في العالم في الثلاثين عاماً المقبلة، إذا لم يتم اتخاذ الإجراءات المناسبة.
وقال فريق الباحثين في هذه الدراسة، الصادرة التي أجراها معهد القياسات الصحية والتقييم في جامعة واشنطن، إن غالبية الحالات مصابة بالنوع الثاني من السكري، المرتبط بالسمنة ويمكن الوقاية منه. وتعد الدراسة، التي مولتها مؤسسة بيل وميليندا غيتس، جزءاً من سلسلة دراسات عن السكري نُشرت أول من أمس بمجلة لانسيت الطبية.